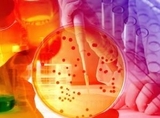

-

세스트린, 자궁내막암세포 증식과 전이 억제 확인
- 2020-09-24 10:55
- 클리닉저널
-

KIMES Busan 2020 개최된다
- 2020-09-24 10:41
- 김향숙 기자
-

보라매병원, 91세 고령환자 ‘관상동맥 우회술’ 성공
- 2020-07-03 14:58
- 클리닉저널
-

용인세브란스 심장초음파검사 한 달에 1,000례 넘어
- 2020-07-03 14:49
- 클리닉저널
-

대장암·폐암 치료 잘 하는 병원 전국 권역에 포진
- 2020-06-15 10:20
- 김성환 기자
-

만성질환 있는 젊은 층도 심방세동 위험 높다
- 2020-06-08 15:36
- 클리닉저널
-

고혈압·당뇨 적정성평가 양호의료기관 전국에 고루 분포
- 2020-05-20 14:44
- 김향숙 기자
-

KIMES 전시회 취소에도 불구 장학금 지급
- 2020-05-14 11:35
- 김향숙 기자
-

무릎인공관절 수술 후 통증지속은 ‘중추신경감작’이 원인
- 2020-05-14 11:09
- 김향숙 기자
-

고혈압 오래 앓을수록 심방세동 위험 증가한다
- 2020-05-12 11:21
- 김향숙기자
-

건선치료에 자외선 LED광선 효과 확인
- 2020-05-12 10:30
- 김향숙 기자
-

젊은 유방암 환자 항암치료후 요추·대퇴골 골손실 발생
- 2020-04-16 10:54
- 김향숙 기자
-

코로나19 바이러스 1시간 내 검출 新기술 개발
- 2020-03-06 10:42
- 김향숙 기자
-

20년 사이 20대, 알코올성 간질환 가장 크게 증가
- 2019-11-26 16:57
- 김향숙 기자
-

노년기 복부내장지방 치매 발병 위험성 높인다
- 2019-11-07 11:00
- 김향숙 기자
-

우리나라 심근경색 환자 LDL 콜레스테롤 관리 미흡
- 2019-11-06 16:04
- 김향숙 기자
-

갑상선 재발암 고주파치료 5년 후 경과도 우수
- 2019-11-06 15:05
- 김향숙 기자
-

동맥경화 진행 예측 혈액 검사로 가능
- 2019-10-30 16:48
- 김향숙 기자
-
간접문합술, 뇌졸중 예방 효과 입증
- 2019-10-24 16:51
- 김향숙 기자
-
유방암 3D 수술 가이드 모델 적용 수술 우수
- 2019-10-23 13:48
- 김향숙기자
-

장내 염증반응을 억제하는 기전 밝혀
- 2019-10-17 13:53
- 클리닉저널
-

경희의료원, 개원 48주년 기념식 개최
- 2019-10-04 17:30
- 클리닉저널
-

심뇌혈관질환자, 신체활동 많을수록 사망위험 감소
- 2019-09-03 13:22
- 클리닉저널
-

수면무호흡증 방치하면 뇌 조직 손상돼 뇌 기능 떨어진다
- 2019-08-21 13:43
- 김향숙기자
- 1 난치성 유방암 표적 항암 신약 후보물질 ‘MKI-3’개발
- 2 `젊다고 예외 없다. 20~30대도 늘어나는 '녹내장'
- 3 봄철, 양치질 열심히 해도 유독 입냄새 심한 원인은?
- 4 유전성 혈관부종(HAE) 예방 중심 치료 본격화
- 5 서울시병원회 이정재 순천향대 의료원장에게 SP자랑스런병원인상 수여
- 6 서울시 장애인치과병원 장애인 구강보건 돌봄역량 강화 교육
- 7 한쪽 눈떨림 반복되고 점차 얼굴 한쪽으로 퍼지면 ‘반측성 안면경련’ 의심
- 8 췌장암 방사선치료 효과 높이는 원리 규명
- 9 봄나들이 앞둔 중장년층, 퇴행성 관절염 점검 필요
- 10 조철환 ETC부문장김명훈 종병영업부장등 이사승진